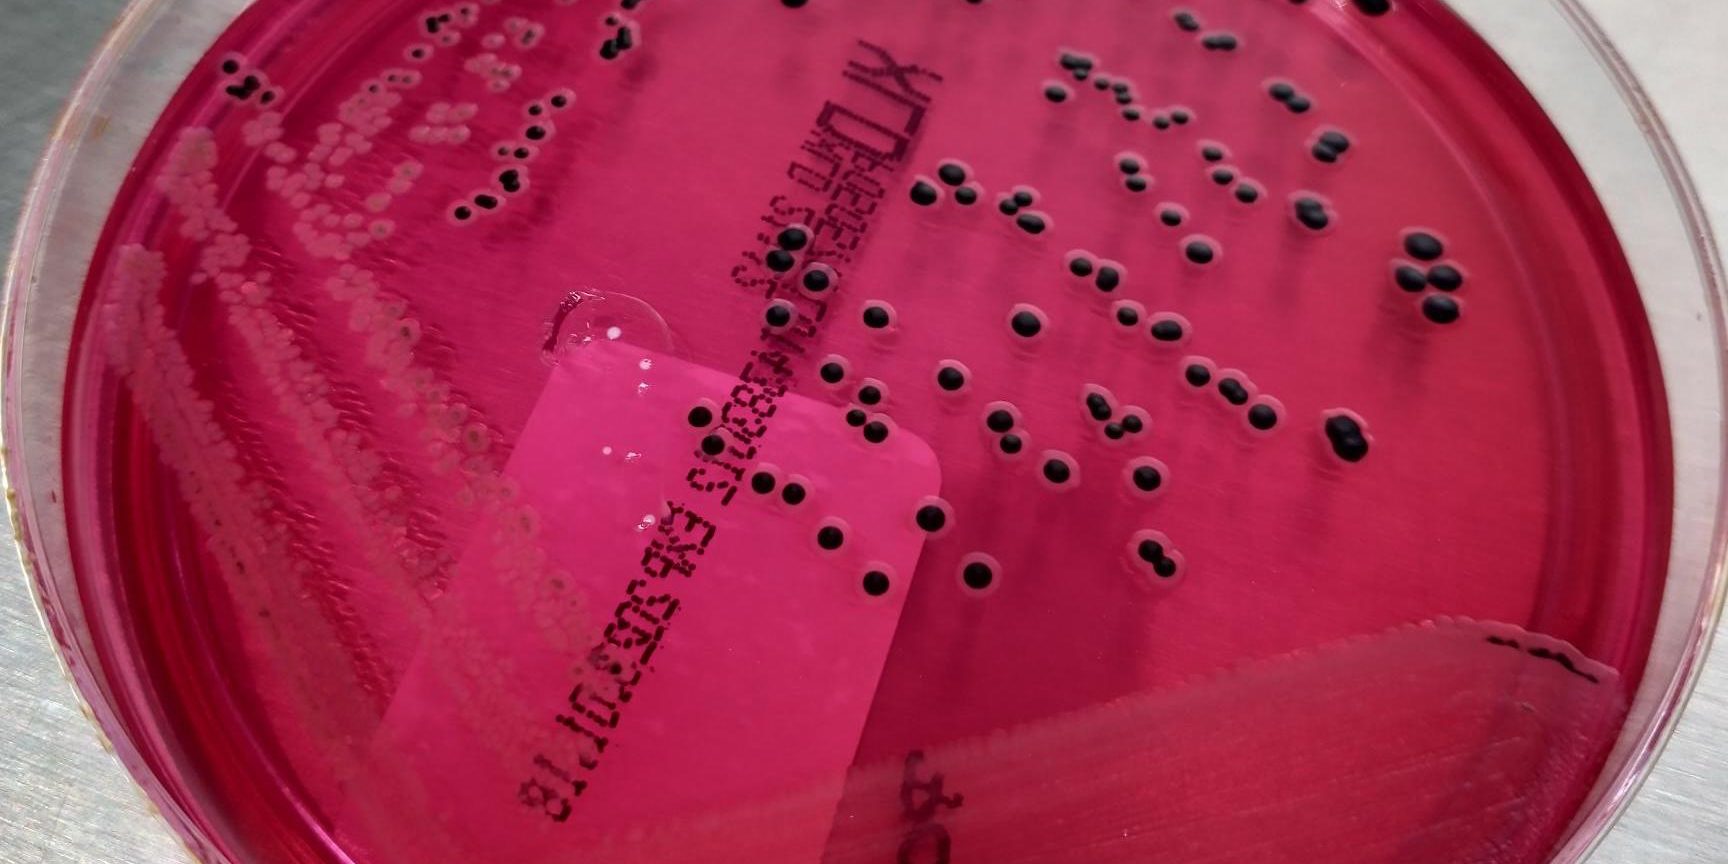

La Salmonella es una bacteria que pertenece a la familia Enterobacteriaceae que puede afectar a varias especies de animales y humanos.
Provoca en gazapos enteritis-diarrea y vía septicémica puede colonizar el hígado, bazo, pulmón, cerebro, articulaciones y aparato reproductor, causando metritis y mortalidad embrionaria en conejas, siendo este el principal cuadro clínico de las conejas.
Su transmisión horizontal directa por vía fecal-oral hace que sea fácilmente transmisible en toda la granja.
Es por eso por lo que el tratamiento de la Salmonelosis es importante que sea eficiente y se pueda aplicar de manera rápida.
En Zenit no únicamente diagnosticamos de forma rápida, sino que también ofrecemos diversos tratamientos eficaces como puede ser la autovacuna.
¿Hablamos?